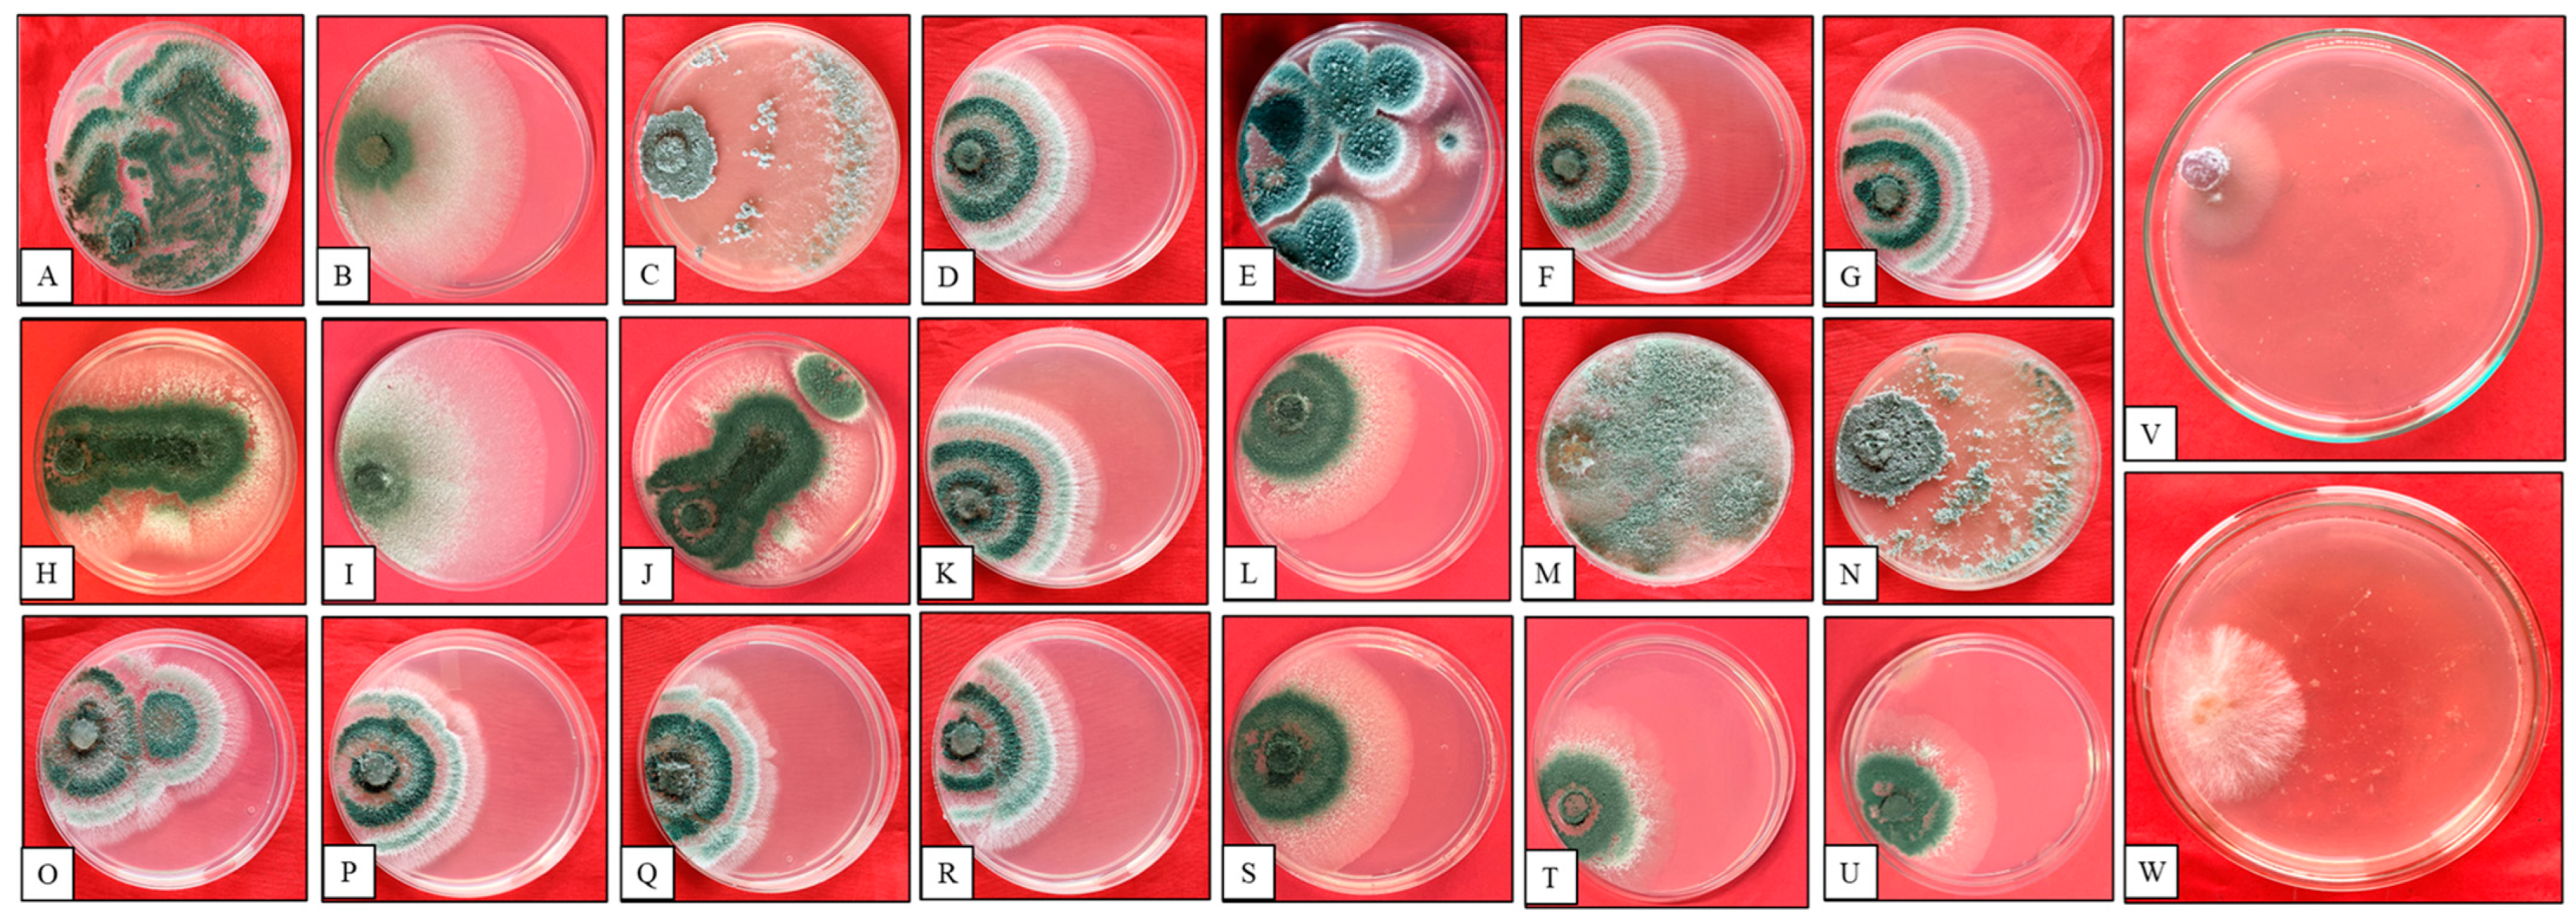
Microorganisms 12 01280 g001

Screening of the Biocontrol Efficacy of Potent Trichoderma Strains against Fusarium oxysporum f.sp. ciceri and Scelrotium rolfsii Causing Wilt and Collar Rot in Chickpea
Abstract
1. Introduction
2. Materials and Methods
2.1. Pathogenic Strains
2.2. Collection of Rhizospheric Soil Samples
2.3. Isolation of Trichoderma sp.
2.4. Molecular Characterization of Trichoderma sp.
2.5. Biocontrol of Trichoderma Isolates on FOC and SR Pathogens
2.5.1. Evaluation of Growth Rate of Trichoderma Isolates/Pathogens
2.5.2. Dual Culture Assay
2.5.3. Cell Wall Degradation Enzymatic Assay
2.5.4. β-1,3-Glucanase Assay
2.5.5. Chitinase Assay
2.5.6. Extraction and Identification of Secondary Metabolites
2.5.7. Statistical Analysis
3. Results
3.1. Isolation of Trichoderma from the Rhizosphere
3.1.1. Antagonistic Activity of Trichoderma Isolates against FOC and SR
3.1.2. Estimation of Chitinase and β-1,3-Glucanase Activities
3.1.3. β-1,3-Glucanase Activity
3.1.4. Molecular Identification of Trichoderma Isolates
3.1.5. GC-MS Analysis
4. Discussion
4.1. Antagonistic Activity
4.2. Enzyme Activity (Chitinase and β-1,3-Glucanase)
4.3. Molecular Identification of Trichoderma Isolates
4.4. GCMS Analysis
5. Conclusions
Author Contributions
Funding
Data Availability Statement
Acknowledgments
Conflicts of Interest
References
- Zhang, J.; Wang, J.; Zhu, C.; Singh, R.P. Chickpea: Its Origin, Distribution, Nutrition, Benefits, Breeding, and Symbiotic Relationship with Mesorhizobium Species. Plants 2024, 13, 429. [Google Scholar] [CrossRef] [PubMed]
- Langyan, S.; Yadava, P.; Khan, F.N.; Bhardwaj, R.; Tripathi, K.; Bhardwaj, V.; Bhardwaj, R.; Gautam, R.K.; Kumar, A. Nutritional and Food Composition Survey of Major Pulses Toward Healthy, Sustainable, and Biofortified Diets. Front. Sustain. Food Syst. 2022, 6, 878269. [Google Scholar] [CrossRef]
- Fikre, A.; Desmae, H.; Ahmed, S. Tapping the Economic Potential of Chickpea in Sub-Saharan Africa. Agronomy 2020, 10, 1707. [Google Scholar] [CrossRef]
- Jiménez-Díaz, R.M.; Castillo, P.; Jiménez-Gasco, M.d.M.; Landa, B.B.; Navas-Cortés, J.A. Fusarium wilt of chickpeas: Biology, ecology and management. Crop Prot. 2015, 73, 16–27. [Google Scholar] [CrossRef]
- Biofortification, D.; Koul, B.; Sharma, K.; Sehgal, V.; Yadav, D.; Mishra, M. Chickpea (Cicer arietinum L.) Biology and Biotechnology: From Domestication to Biofortification and Biopharming. Plants 2022, 11, 2926. [Google Scholar] [CrossRef] [PubMed]
- Merga, B.; Haji, J. Economic importance of chickpea: Production, value, and world trade. Cogent Food Agric. 2019, 5, 1615718. [Google Scholar] [CrossRef]
- Rani, A.; Devi, P.; Jha, U.C.; Sharma, K.D.; Siddique, K.H.M.; Nayyar, H. Developing Climate-Resilient Chickpea Involving Physiological and Molecular Approaches with a Focus on Temperature and Drought Stresses. Front. Plant Sci. 2020, 10, 1759. [Google Scholar] [CrossRef] [PubMed]
- Ghosh, R.; Sharma, M.; Telangre, R.; Pande, S. Occurrence and Distribution of Chickpea Diseases in Central and Southern Parts of India. Am. J. Plant Sci. 2013, 4, 940–944. [Google Scholar] [CrossRef]
- Begum, N.; Khan, Q.U.; Liu, L.G.; Li, W.; Liu, D.; Haq, I.U. Nutritional composition, health benefits and bio-active compounds of chickpea (Cicer arietinum L.). Front. Nutr. 2023, 10, 1218468. [Google Scholar] [CrossRef] [PubMed]
- Khan, I.H.; Javaid, A.; Al-Taie, A.H.; Ahmed, D. Use of Neem leaves as soil amendment for the control of collar rot disease of chickpea. Egypt. J. Biol. Pest Control 2020, 30, 98. [Google Scholar] [CrossRef]
- Foresto, E.; Carezzano, M.E.; Giordano, W.; Bogino, P. Ascochyta Blight in Chickpea: An Update. J. Fungi 2023, 9, 203. [Google Scholar] [CrossRef] [PubMed]
- Jendoubi, W.; Bouhadida, M.; Boukteb, A.; Béji, M.; Kharrat, M. Fusarium wilt affecting chickpea crop. Agriculture 2017, 7, 23. [Google Scholar] [CrossRef]
- Pande, S.; Sharma, M.; Ghosh, R.; Rameshwar, T.; Reddy, D.R. Chickpea diseases and insect-pest management. Legumes Pathol. 2011, 1–14. [Google Scholar]
- Tarafdar, A.; Rani, T.S.; Chandran, U.S.S.; Ghosh, R.; Chobe, D.R.; Sharma, M. Exploring combined effect of abiotic (soil moisture) and biotic (Sclerotium rolfsii sacc.) stress on collar rot development in chickpea. Front. Plant Sci. 2018, 9, 1154. [Google Scholar] [CrossRef] [PubMed]
- Panth, M.; Hassler, S.C.; Baysal-Gurel, F. Methods for management of soilborne diseases in crop production. Agriculture 2020, 10, 16. [Google Scholar] [CrossRef]
- Dita, M.; Barquero, M.; Heck, D.; Mizubuti, E.S.G.; Staver, C.P. Fusarium wilt of banana: Current knowledge on epidemiology and research needs toward sustainable disease management. Front. Plant Sci. 2018, 871, 1468. [Google Scholar] [CrossRef] [PubMed]
- Pandey, G.K.; Ahmad, S.; Zacharia, S. Management of Chick Pea Wilt Caused by Fusarium oxysporum F. Sp. Ciceri. Asian J. Pharm. Res. 2018, 8, 158. [Google Scholar] [CrossRef]
- Fanning, J.; Brand, J.; Munoz Santa, I.; McDonald, L.; Taylor, J.; Hollaway, G. Management of chickpea Ascochyta blight using fungicides and cultivar resistance improves grain yield, quality, and grower profitability. Front. Plant Sci. 2022, 13, 942220. [Google Scholar] [CrossRef] [PubMed]
- Wise, K.A.; Henson, R.A.; Bradley, C.A. Fungicide seed treatment effects on seed-borne ascochyta rabiei in chickpea. Horttechnology 2009, 19, 533–537. [Google Scholar] [CrossRef]
- Zubrod, J.P.; Bundschuh, M.; Arts, G.; Brühl, C.A.; Imfeld, G.; Knäbel, A.; Payraudeau, S.; Rasmussen, J.J.; Rohr, J.; Scharmüller, A.; et al. Fungicides: An Overlooked Pesticide Class? Environ. Sci. Technol. 2019, 53, 3347–3365. [Google Scholar] [CrossRef] [PubMed]
- Alo, F.; Rani, A.R.; Baum, M.; Singh, S.; Kehel, Z.; Rani, U.; Udupa, S.; Al-Sham’aa, K.; Alsamman, A.M.; Istanbuli, T.; et al. Novel Genomic Regions Linked to Ascochyta Blight Resistance in Two Differentially Resistant Cultivars of Chickpea. Front. Plant Sci. 2022, 13, 762002. [Google Scholar] [CrossRef] [PubMed]
- Rai, A.; Irulappan, V.; Senthil-Kumar, M. Dry Root Rot of Chickpea: A Disease Favored by Drought. Plant Dis. 2022, 106, 346–356. [Google Scholar] [CrossRef] [PubMed]
- Boyd, L.A.; Ridout, C.; O’Sullivan, D.M.; Leach, J.E.; Leung, H. Plant-pathogen interactions: Disease resistance in modern agriculture. Trends Genet. 2013, 29, 233–240. [Google Scholar] [CrossRef] [PubMed]
- Nelson, R.; Wiesner-Hanks, T.; Wisser, R.; Balint-Kurti, P. Navigating complexity to breed disease-resistant crops. Nat. Rev. Genet. 2018, 19, 21–33. [Google Scholar] [CrossRef] [PubMed]
- Schreiter, S.; Sandmann, M.; Smalla, K.; Grosch, R. Soil type dependent rhizosphere competence and biocontrol of two bacterial inoculant strains and their effects on the rhizosphere microbial community of field-grown lettuce. PLoS ONE 2014, 9, e103726. [Google Scholar] [CrossRef] [PubMed]
- Toyota, K.; Shirai, S. Growing interest in microbiome research unraveling disease suppressive soils against plant pathogens. Microbes Environ. 2018, 33, 345–347. [Google Scholar] [CrossRef] [PubMed]
- Dlamini, S.P.; Akanmu, A.O.; Babalola, O.O. Rhizospheric microorganisms: The gateway to a sustainable plant health. Front. Sustain. Food Syst. 2022, 6, 925802. [Google Scholar] [CrossRef]
- Ciancio, A.; Rosso, L.C.; Lopez-Cepero, J.; Colagiero, M. Rhizosphere 16S-ITS Metabarcoding Profiles in Banana Crops Are Affected by Nematodes, Cultivation, and Local Climatic Variations. Front. Microbiol. 2022, 13, 855110. [Google Scholar] [CrossRef] [PubMed]
- Pacifico, D.; Squartini, A.; Crucitti, D.; Barizza, E.; Lo Schiavo, F.; Muresu, R.; Carimi, F.; Zottini, M. The Role of the Endophytic Microbiome in the Grapevine Response to Environmental Triggers. Front. Plant Sci. 2019, 10, 1256. [Google Scholar] [CrossRef] [PubMed]
- Sundaramoorthy, S.; Raguchander, T.; Ragupathi, N.; Samiyappan, R. Combinatorial effect of endophytic and plant growth promoting rhizobacteria against wilt disease of Capsicum annum L. caused by Fusarium solani. Biol. Control 2012, 60, 59–67. [Google Scholar] [CrossRef]
- Emami, S.; Alikhani, H.A.; Pourbabaei, A.A.; Etesami, H.; Sarmadian, F.; Motessharezadeh, B. Effect of rhizospheric and endophytic bacteria with multiple plant growth promoting traits on wheat growth. Environ. Sci. Pollut. Res. 2019, 26, 19804–19813. [Google Scholar] [CrossRef] [PubMed]
- Poveda, J.; Eugui, D. Combined use of Trichoderma and beneficial bacteria (mainly Bacillus and Pseudomonas): Development of microbial synergistic bio-inoculants in sustainable agriculture. Biol. Control 2022, 176, 105100. [Google Scholar] [CrossRef]
- Ferreira, F.V.; Musumeci, M.A. Trichoderma as biological control agent: Scope and prospects to improve efficacy. World J. Microbiol. Biotechnol. 2021, 37, 90. [Google Scholar] [CrossRef] [PubMed]
- Dennis, C.; Webster, J. Antagonistic properties of species-groups of Trichoderma: I. Production of non-volatile antibiotics. Trans. Br. Mycol. Soc. 1971, 57, 25-IN3. [Google Scholar] [CrossRef]
- Sarrocco, S. Biological Disease Control by Beneficial (Micro)Organisms: Selected Breakthroughs in the Past 50 Years. Phytopathology 2023, 113, 732–740. [Google Scholar] [CrossRef]
- Collinge, D.B.; Jensen, D.F.; Rabiey, M.; Sarrocco, S.; Shaw, M.W.; Shaw, R.H. Biological control of plant diseases—What has been achieved and what is the direction? Plant Pathol. 2022, 71, 1024–1047. [Google Scholar] [CrossRef]
- Manganiello, G.; Nicastro, N.; Caputo, M.; Zaccardelli, M.; Cardi, T.; Pane, C. Functional Hyperspectral Imaging by High-Related Vegetation Indices to Track the Wide-Spectrum Trichoderma Biocontrol Activity against Soil-Borne Diseases of Baby-Leaf Vegetables. Front. Plant Sci. 2021, 12, 630059. [Google Scholar] [CrossRef] [PubMed]
- Lyubenova, A.; Rusanova, M.; Nikolova, M.; Slavov, S.B. Plant extracts and Trichoderma spp.: Possibilities for implementation in agriculture as biopesticides. Biotechnol. Biotechnol. Equip. 2023, 37, 159–166. [Google Scholar] [CrossRef]
- Dindal, D.L. Methods for Research on the Ecology of Soil Borne Plant Pathogens. Soil Sci. Soc. Am. J. 1972, 36, iv. [Google Scholar] [CrossRef]
- Saravanakumar, K.; Wang, M.H. Isolation and molecular identification of Trichoderma species from wetland soil and their antagonistic activity against phytopathogens. Physiol. Mol. Plant Pathol. 2020, 109, 101458. [Google Scholar] [CrossRef]
- Dou, K.; Gao, J.; Zhang, C.; Yang, H.; Jiang, X.; Li, J.; Li, Y.; Wang, W.; Xian, H.; Li, S.; et al. Trichoderma biodiversity in major ecological systems of China. J. Microbiol. 2019, 57, 668–675. [Google Scholar] [CrossRef] [PubMed]
- Jaklitsch, W.M.; Voglmayr, H. Biodiversity of Trichoderma (Hypocreaceae) in Southern Europe and Macaronesia. Stud. Mycol. 2015, 80, 1–87. [Google Scholar] [CrossRef] [PubMed]
- Matas-Baca, M.Á.; Urías García, C.; Pérez-Álvarez, S.; Flores-Córdova, M.A.; Escobedo-Bonilla, C.M.; Magallanes-Tapia, M.A.; Sánchez Chávez, E. Morphological and molecular characterization of a new autochthonous Trichoderma sp. isolate and its biocontrol efficacy against Alternaria sp. Saudi J. Biol. Sci. 2022, 29, 2620–2625. [Google Scholar] [CrossRef] [PubMed]
- Kumar, M.; Shukla, P.K. Use of PCR targeting of internal transcribed spacer regions and single-stranded conformation polymorphism analysis of sequence variation in different regions of rRNA genes in fungi for rapid diagnosis of mycotic keratitis. J. Clin. Microbiol. 2005, 43, 662–668. [Google Scholar] [CrossRef] [PubMed]
- Al-Salihi, S.A.A.; Alberti, F. Genomic Based Analysis of the Biocontrol Species Trichoderma harzianum: A Model Resource of Structurally Diverse Pharmaceuticals and Biopesticides. J. Fungi 2023, 9, 895. [Google Scholar] [CrossRef] [PubMed]
- Kim, S.H.; Lee, Y.; Balaraju, K.; Jeon, Y. Evaluation of Trichoderma atroviride and Trichoderma longibrachiatum as biocontrol agents in controlling red pepper anthracnose in Korea. Front. Plant Sci. 2023, 14, 1201875. [Google Scholar] [CrossRef] [PubMed]
- Kangjam, V.; Pongener, N.; Singh, R.; Banik, S.; Daiho, L.; Ao, N.T. In vitro screening for potential antagonistic activity of Trichoderma isolates against Sclerotium rolfsii causing collar rot of French bean. Environ. Ecol. 2023, 41, 623–632. [Google Scholar]
- Dubey, S.C.; Suresh, M.; Singh, B. Evaluation of Trichoderma species against Fusarium oxysporum f.sp. ciceris for integrated management of chickpea wilt. Biol. Control 2007, 40, 118–127. [Google Scholar] [CrossRef]
- Paul, N.C.; Park, S.; Liu, H.; Lee, J.G.; Han, G.H.; Kim, H.; Sang, H. Fungi associated with postharvest diseases of sweet potato storage roots and in vitro antagonistic assay of trichoderma harzianum against the diseases. J. Fungi 2021, 7, 927. [Google Scholar] [CrossRef] [PubMed]
- Qualhato, T.F.; Lopes, F.A.C.; Steindorff, A.S.; Brandão, R.S.; Jesuino, R.S.A.; Ulhoa, C.J. Mycoparasitism studies of Trichoderma species against three phytopathogenic fungi: Evaluation of antagonism and hydrolytic enzyme production. Biotechnol. Lett. 2013, 35, 1461–1468. [Google Scholar] [CrossRef] [PubMed]
- Saravanakumar, K.; Yu, C.; Dou, K.; Wang, M.; Li, Y.; Chen, J. Synergistic effect of Trichoderma-derived antifungal metabolites and cell wall degrading enzymes on enhanced biocontrol of Fusarium oxysporum f. sp. cucumerinum. Biol. Control 2016, 94, 37–46. [Google Scholar] [CrossRef]
- Agrawal, T.; Kotasthane, A.S.; Mousumi Das, M.; Haridas, M.; Sabu, A.; Kumar, K.; Amaresan, N.; Bhagat, S.; Madhuri, K.; Srivastava, R.C.; et al. Effect of culture media, pH and temperature on the mycelial growth and sporulation of Fusarium oxysporum f.sp ciceris isolates of chickpea from Central Zone of India. J. Fungi 2022, 94, 57–65. [Google Scholar] [CrossRef]
- Mazrou, Y.S.A.; Makhlouf, A.H.; Elseehy, M.M.; Awad, M.F.; Hassan, M.M. Antagonistic activity and molecular characterization of biological control agent Trichoderma harzianum from Saudi Arabia. Egypt. J. Biol. Pest Control 2020, 30, 4. [Google Scholar] [CrossRef]
- Shobha, B.; Lakshmeesha, T.R.; Ansari, M.A.; Almatroudi, A.; Alzohairy, M.A.; Basavaraju, S.; Alurappa, R.; Niranjana, S.R.; Chowdappa, S. Mycosynthesis of zno nanoparticles using trichoderma spp. Isolated from rhizosphere soils and its synergistic antibacterial effect against xanthomonas oryzae pv. oryzae. J. Fungi 2020, 6, 181. [Google Scholar] [CrossRef] [PubMed]
- Lakhdari, W.; Benyahia, I.; Bouhenna, M.M.; Bendif, H.; Khelafi, H.; Bachir, H.; Ladjal, A.; Hammi, H.; Mouhoubi, D.; Khelil, H.; et al. Exploration and Evaluation of Secondary Metabolites from Trichoderma harzianum: GC-MS Analysis, Phytochemical Profiling, Antifungal and Antioxidant Activity Assessment. Molecules 2023, 28, 5025. [Google Scholar] [CrossRef] [PubMed]
- Mulatu, A.; Megersa, N.; Tolcha, T.; Alemu, T.; Vetukuri, R.R. Antifungal compounds, GC-MS analysis and toxicity assessment of methanolic extracts of Trichoderma species in an animal model. PLoS ONE 2022, 17, e0274062. [Google Scholar] [CrossRef] [PubMed]
- Stracquadanio, C.; Quiles, J.M.; Meca, G.; Cacciola, S.O. Antifungal activity of bioactive metabolites produced by trichoderma asperellum and trichoderma atroviride in liquid medium. J. Fungi 2020, 6, 263. [Google Scholar] [CrossRef] [PubMed]
- Oviya, R.; Thiruvudainambi, S.; Ramamoorthy, V.; Thamizh Vendan, R.; Vellaikumar, S. Antagonistic potential of Trichoderma hamatum against Alternaria porri causing purple blotch disease of onion through Gas chromatography-mass spectrometry (GCMS) analysis. J. Appl. Nat. Sci. 2022, 14, 1031–1038. [Google Scholar] [CrossRef]
- Shilov, S.V.; Ustenova, G.O.; Kiyekbayeva, L.N.; Korotetskiy, I.S.; Kudashkina, N.V.; Zubenko, N.V.; Parenova, R.A.; Jumagaziyeva, A.B.; Iskakbayeva, Z.A.; Kenesheva, S.T. Component Composition and Biological Activity of Various Extracts of Onosma gmelinii (Boraginaceae). Int. J. Biomater. 2022, 2022, 4427804. [Google Scholar] [CrossRef] [PubMed]
- Rowshanul, M.; Habib, M. Rezaul Karim Antimicrobial and Cytotoxic Activity of Di-(2-ethylhexyl) Phthalate and Anhy- drosophoradiol-3-acetate Isolated from Calotropis gigantea (Linn.) Flower. Mycobiology 2009, 37, 31–36. [Google Scholar]

| Sr. no. | Isolates | Location | Growth with Respect to FOC (cm) | Growth Rate with Respect to SR (cm) | Percentage Inhibition of FOC | Percentage Inhibition of SR |
|---|---|---|---|---|---|---|
| 1. | PBT1 | Faridkot | 1.55 ± 0.15 bc | 0.9 ± 0.09 bc | 68.52 ± 8.48 bc | 38.9 ± 5.56 ik |
| 2. | PBT2 | Barnala | 1.30 ± 0.74 d | 0.8 ± 0.42 c | 61.12 ± 5.56 cd | 51.9 ± 6.41 cdef |
| 3. | PBT3 | Bathinda | 2.53 ± 0.13 ab | 1.5 ± 0.03 a | 72.23 ± 5.56 b | 59.3 ± 6.41 bc |
| 4. | PBT4 | Amritsar | 2.22 ± 0.56 abc | 1.3 ± 0.33 ab | 70.00 ± 4.00 bc | 55.6 ± 5.56 bcd |
| 5. | PBT5 | Fatehpur Sahib | 1.02 ± 0.70 c | 0.6 ± 0.34 c | 58.52 ± 2.80 d | 45.6 ± 4.00 efghi |
| 6. | PBT6 | Fazilka | 1.63 ± 0.09 cd | 0.9 ± 0.05 bc | 69.26 ± 2.80 bc | 41.1 ± 2.23 hij |
| 7. | PBT7 | Ferozpur | 1.35 ± 0.09 d | 0.8 ± 0.05 c | 62.60 ± 3.40 cd | 49.3 ± 5.70 defg |
| 8. | PBT8 | Gurdaspur | 1.20 ± 0.56 d | 0.7 ± 0.33 c | 61.12 ± 5.56 cd | 44.1 ± 1.70 fghij |
| 9. | PBT9 | Malerkotla | 2.51 ± 0.12 ab | 1.5 ± 0.00 a | 72.23 ± 5.56 b | 55.9 ± 1.70 bcd |
| 10. | PBT10 | J&K | 1.24 ± 0.43 d | 0.7 ± 0.24 c | 60.75 ± 6.12 cd | 47.0 ± 2.79 efgh |
| 11. | PBT11 | Jalandhar | 1.64 ± 0.11 cd | 1.0 ± 0.07 bc | 62.23 ± 4.01 cd | 45.2 ± 1.28 efghi |
| 12. | PBT12 | Kapurthala | 1.33 ± 0.28 d | 0.8 ± 0.16 c | 57.41 ± 1.70 d | 52.6 ± 2.80 cde |
| 13. | PBT13 | Ludhiana | 2.61 ± 0.06 a | 1.6 ± 0.05 a | 72.97 ± 5.01 b | 61.1 ± 5.56 b |
| 14. | PBT14 | Himachal Pradesh | 1.60 ± 0.85 cd | 0.9 ± 0.49 bc | 69.26 ± 2.80 bc | 53.0 ± 2.80 cde |
| 15. | PBT15 | Mansa | 1.75 ± 0.43 bcd | 1.0 ± 0.25 bc | 58.15 ± 2.80 d | 50.0 ± 5.56 def |
| 16. | PBT16 | Moga | 1.57 ± 0.12 cd | 0.9 ± 0.07 bc | 66.67 ± 2.22 bcd | 36.3 ± 2.79 j |
| 17. | PBT17 | Muktsar | 1.52 ± 0.09 cd | 0.9 ± 0.05 bc | 66.30 ± 2.79 bcd | 41.9 ± 2.80 ghij |
| 18. | PBT18 | Nawanshahr | 1.57 ± 0.14 cd | 0.9 ± 0.09 bc | 61.49 ± 7.14 cd | 50.4 ± 5.01 def |
| 19. | PBT19 | Patiala | 1.05 ± 0.16 d | 0.6 ± 0.09 c | 61.12 ± 5.56 cd | 50.4 ± 5.01 def |
| 20. | PBT20 | Sangrur | 1.49 ± 1.08 cd | 0.8 ± 0.49 c | 65.93 ± 5.60 bcd | 46.3 ± 3.39 efghi |
| 21. | PBT21 | Tarn Taran | 1.11 ± 0.28 d | 0.6 ± 0.16 c | 61.12 ± 5.56 cd | 49.3 ± 4.49 defg |
| Control | - | - | 90.00 ± 0 | 90.0 ± 0 | ||
| CD | 0.737 | 0.397 | 7.812 | 6.930 | ||
| SE(d) | 0.364 | 0.196 | 3.863 | 3.427 |
| S.no. | Isolates | β-1,3-Glucanase Activity (μmole min−1) | Chitinase Activity/Zone Formation (cm) |
|---|---|---|---|
| 1 | PBT1 | 1.407 | 4.00 ± 0.50 abcd |
| 2 | PBT2 | 0.828 | 2.17 ± 0.76 fgh |
| 3 | PBT3 | 1.511 | 4.33 ± 0.29 ab |
| 4 | PBT4 | 1.442 | 4.23 ± 0.25 abc |
| 5 | PBT5 | 1.048 | 0.00 ± 0.00 h |
| 6 | PBT6 | 1.349 | 3.67 ± 0.7 6 abcde |
| 7 | PBT7 | 1.025 | 3.33 ± 0.29 abcdefg |
| 8 | PBT8 | 1.28 | 3.17 ± 1.15 abcdefg |
| 9 | PBT9 | 1.488 | 4.33 ± 0.29 ab |
| 10 | PBT10 | 0.898 | 2.67 ± 2.08 defgh |
| 11 | PBT11 | 0.666 | 4.03 ± 0.06 abc |
| 12 | PBT12 | 1.187 | 0.00 ± 0.00 i |
| 13 | PBT13 | 1.511 | 4.40 ± 0.17 a |
| 14 | PBT14 | 0.504 | 1.47 ± 0.00 h |
| 15 | PBT15 | 1.245 | 3.97 ± 0.25 abcd |
| 16 | PBT16 | 1.407 | 3.00 ± 1.32 bcdefg |
| 17 | PBT17 | 0.435 | 2.00 ± 0.50 gh |
| 18 | PBT18 | 0.863 | 2.50 ± 0.50 efgh |
| 19 | PBT19 | 1.245 | 2.93 ± 0.21 cdefg |
| 20 | PBT20 | 1.314 | 2.43 ± 0.12 efgh |
| 21 | PBT21 | 1.06 | 3.40 ± 0.53 abcdef |
| Isolate | Identified Species | Total Score | Query Cover (%) | Identity (%) | Accession No. | Genbank Accession No. |
|---|---|---|---|---|---|---|
| PBT3 | T. virens | 967 | 100 | 100 | MN452840.1 | 0N678281 |
| PBT4 | T. asperellum | 1024 | 100 | 100 | MN046976.1 | PP256386 |
| PBT13 | T. harzianum | 1064 | 100 | 100 | MF87546.1 | PP256488 |
| PBT9 | T. lixii | 1064 | 100 | 100 | MK288146.1 | PP256388 |
| Trichoderma harzianum | ||||||
|---|---|---|---|---|---|---|
| Sr. No. | Name of Compound | Molecular Formula | Molecular Weight | RT (min) | Peak Area% | Specific Role |
| 1. | Nonanal | C9H18O | 142 | 8.731 | 0.85 | Antifungal and antibacterial |
| 2. | Acetic acid, 2-ethylhexyl ester | C10H20O2 | 172 | 9.406 | 6.29 | - |
| 3. | Nonanoic acid | C9H18O2 | 158 | 11.249 | 0.71 | - |
| 4. | Benzeneethanol, 4-hydroxy- | C8H10O2 | 138 | 13.500 | 0.53 | Antifungal activity |
| 5. | 2,4-Di-tert-butylphenol | C14H22O | 206 | 14.563 | 0.58 | - |
| 6. | aR-Turmerone | C15H20O | 216 | 16.495 | 1.65 | - |
| 7. | Tetradecanoic acid | C14H28O2 | 228 | 17.513 | 5.47 | - |
| 8. | Hexadecanoic acid, methyl ester | C17H34O2 | 270 | 19.243 | 5.00 | Antifungal activity |
| 9. | n-Hexadecanoic acid | C16H32O2 | 256 | 19.626 | 6.80 | Antifungal activity |
| 10. | 6-Octadecenoic acid, methyl ester, (Z)- | C19H36O2 | 296 | 20.957 | 6.19 | Antifungal activity |
| 11. | 1-Hydroxy-3-methylanthraquinone | C15H10O3 | 238 | 22.201 | 12.24 | - |
| 12. | Hexadecanoic acid, 2-hydroxy-1-(hydroxymethyl)ethyl ester | C19H38O4 | 330 | 24.509 | 2.95 | - |
| 13. | Bis(2-ethylhexyl) phthalate | C24H38O4 | 390 | 24.680 | 5.42 | Antimicrobial activity, Antibacterial activity |
| 14. | Octadecanoic acid, 2,3-dihydroxypropyl ester | C21H42O4 | 358 | 26.095 | 2.36 | Antifungal activity |
| 15. | Tetrapentacontane | C54H110 | 758 | 27.372 | 1.90 | - |
| Trichoderma lixii | ||||||
| Sr No. | Name of compound | Molecular formula | Molecular weight | RT (min) | Peak area% | Specific area |
| 1. | Butanoic acid, 3-hydroxy- | C4H8O3 | 104 | 5.966 | 1.49 | Antibacterial activity |
| 2. | Acetic acid, 2-ethylhexyl ester | C10H20O2 | 172 | 9.408 | 4.61 | - |
| 3. | Benzaldehyde, 4-nitro- | C7H5NO3 | 151 | 12.409 | 1.59 | - |
| 4. | Dehydroacetic acid | C8H8O4 | 168 | 12.704 | 0.58 | Antimicrobial activity |
| 5. | 3H-Pyrazol-3-one, 1,2-dihydro-5-methyl- | C4H6N2O | 98 | 14.535 | 0.57 | - |
| 6. | 2,4-Di-tert-butylphenol | C14H22O | 206 | 14.564 | 0.60 | - |
| 7. | Tetradecanoic acid | C14H28O2 | 238 | 17.518 | 4.54 | Antibacterial activity |
| 8. | 7,9-Di-tert-butyl-1-oxaspiro(4,5)deca-6,9-diene-2,8-dione | C17H24O3 | 276 | 19.114 | 1.52 | - |
| 9. | 1-Hydroxy-3-methylanthraquinone | C15H10O3 | 238 | 22.196 | 1.38 | Antimicrobial activity |
| 10. | Bicyclo[3.3.0]octan-3-one, 6-iodo-2-methyl-, cis | C9H13IO | 264 | 22.489 | 1.41 | - |
| 11. | N,N-Dimethyl-6-[4-methylphenyl]-1,2,4,5-tetrazin-2-amine | C11H13N5 | 215 | 23.569 | 2.48 | - |
| 12. | Bis(2-ethylhexyl) phthalate | C24H38O4 | 390 | 24.685 | 2.31 | Antifungal activity |
| 13. | Chloramphenicol | C11H12Cl2N2O5 | 312 | 26.198 | 42.16 | - |
Disclaimer/Publisher’s Note: The statements, opinions and data contained in all publications are solely those of the individual author(s) and contributor(s) and not of MDPI and/or the editor(s). MDPI and/or the editor(s) disclaim responsibility for any injury to people or property resulting from any ideas, methods, instructions or products referred to in the content. |
© 2024 by the authors. Licensee MDPI, Basel, Switzerland. This article is an open access article distributed under the terms and conditions of the Creative Commons Attribution (CC BY) license (https://creativecommons.org/licenses/by/4.0/).
Share and Cite
Kumari, R.; Kumar, V.; Arukha, A.P.; Rabbee, M.F.; Ameen, F.; Koul, B. Screening of the Biocontrol Efficacy of Potent Trichoderma Strains against Fusarium oxysporum f.sp. ciceri and Scelrotium rolfsii Causing Wilt and Collar Rot in Chickpea. Microorganisms 2024, 12, 1280. https://doi.org/10.3390/microorganisms12071280
Kumari R, Kumar V, Arukha AP, Rabbee MF, Ameen F, Koul B. Screening of the Biocontrol Efficacy of Potent Trichoderma Strains against Fusarium oxysporum f.sp. ciceri and Scelrotium rolfsii Causing Wilt and Collar Rot in Chickpea. Microorganisms. 2024; 12(7):1280. https://doi.org/10.3390/microorganisms12071280
Chicago/Turabian StyleKumari, Ranjna, Vipul Kumar, Ananta Prasad Arukha, Muhammad Fazle Rabbee, Fuad Ameen, and Bhupendra Koul. 2024. "Screening of the Biocontrol Efficacy of Potent Trichoderma Strains against Fusarium oxysporum f.sp. ciceri and Scelrotium rolfsii Causing Wilt and Collar Rot in Chickpea" Microorganisms 12, no. 7: 1280. https://doi.org/10.3390/microorganisms12071280
APA StyleKumari, R., Kumar, V., Arukha, A. P., Rabbee, M. F., Ameen, F., & Koul, B. (2024). Screening of the Biocontrol Efficacy of Potent Trichoderma Strains against Fusarium oxysporum f.sp. ciceri and Scelrotium rolfsii Causing Wilt and Collar Rot in Chickpea. Microorganisms, 12(7), 1280. https://doi.org/10.3390/microorganisms12071280

